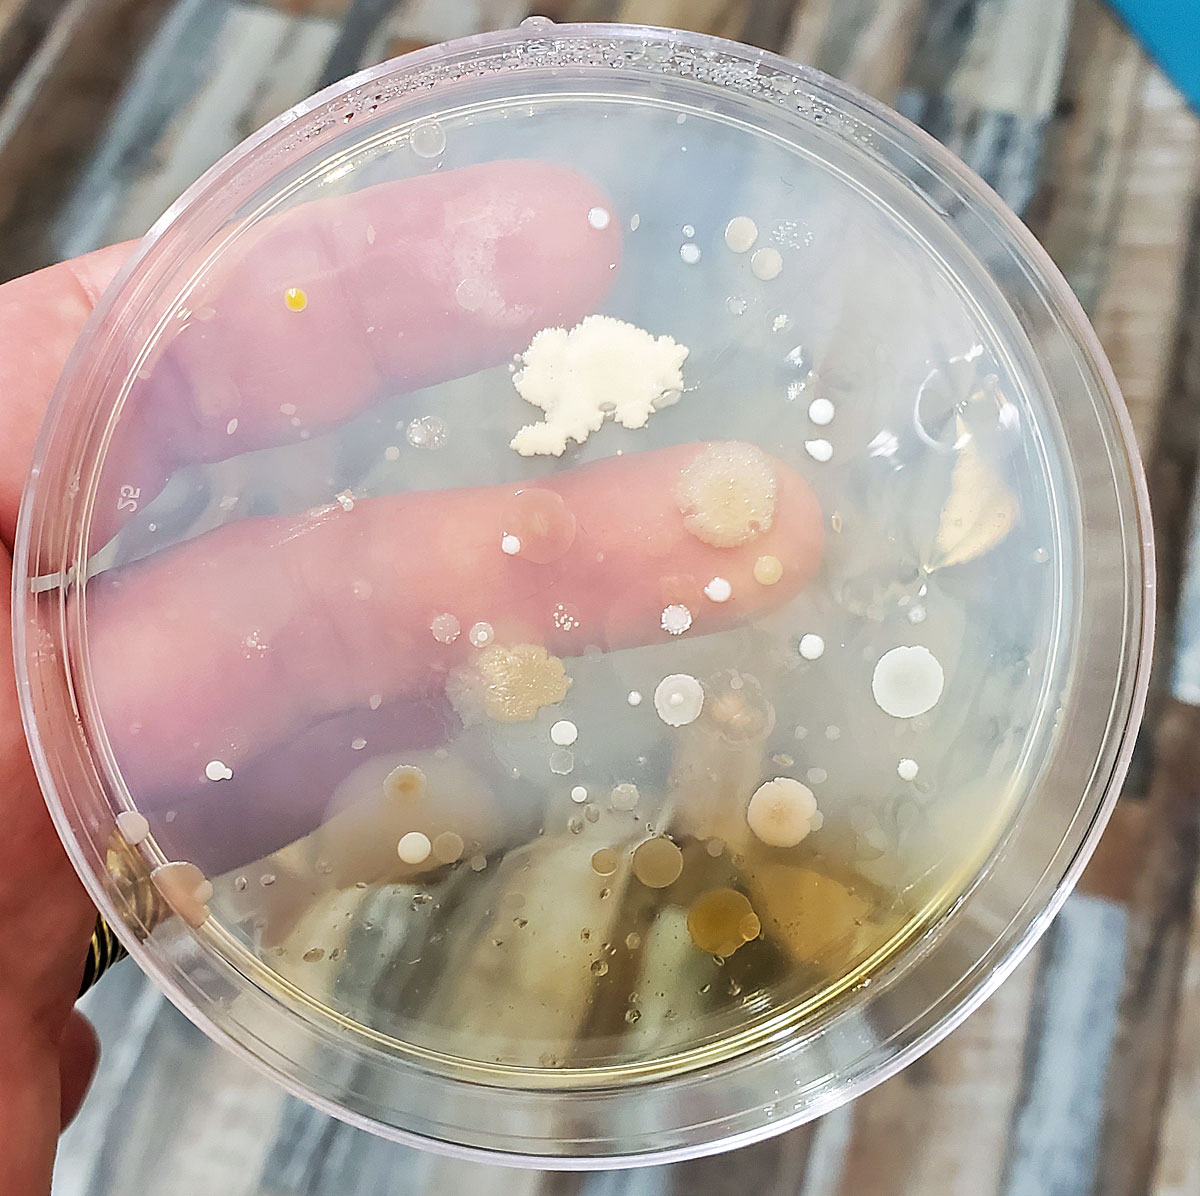
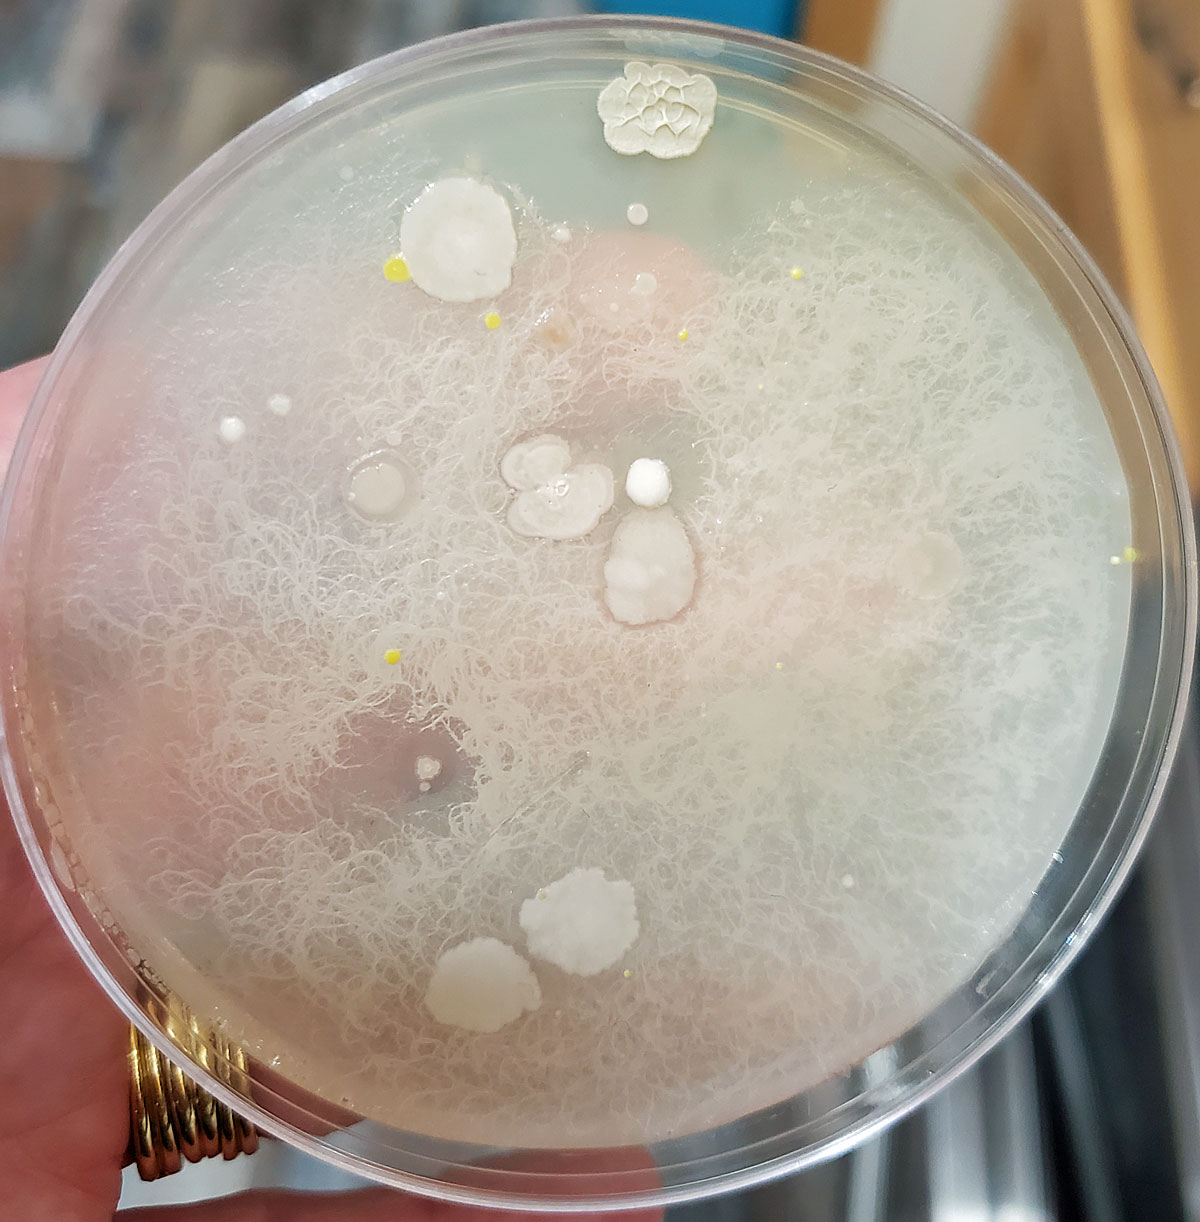
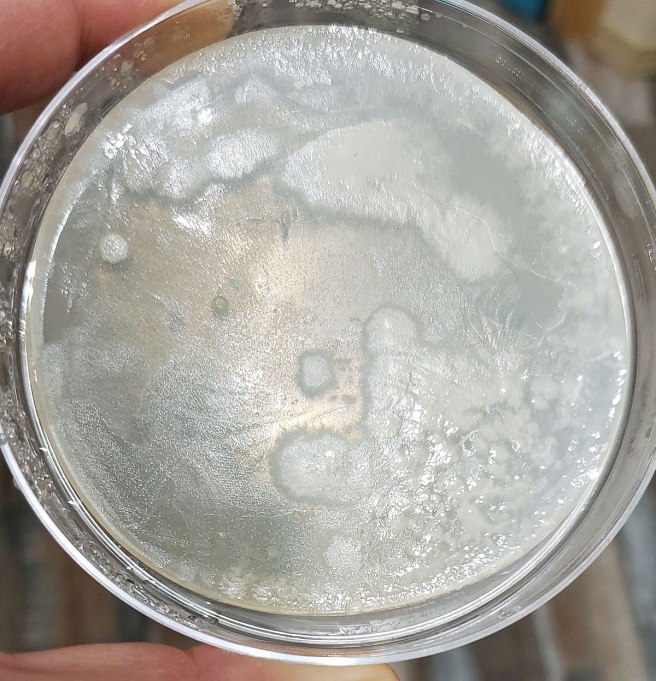
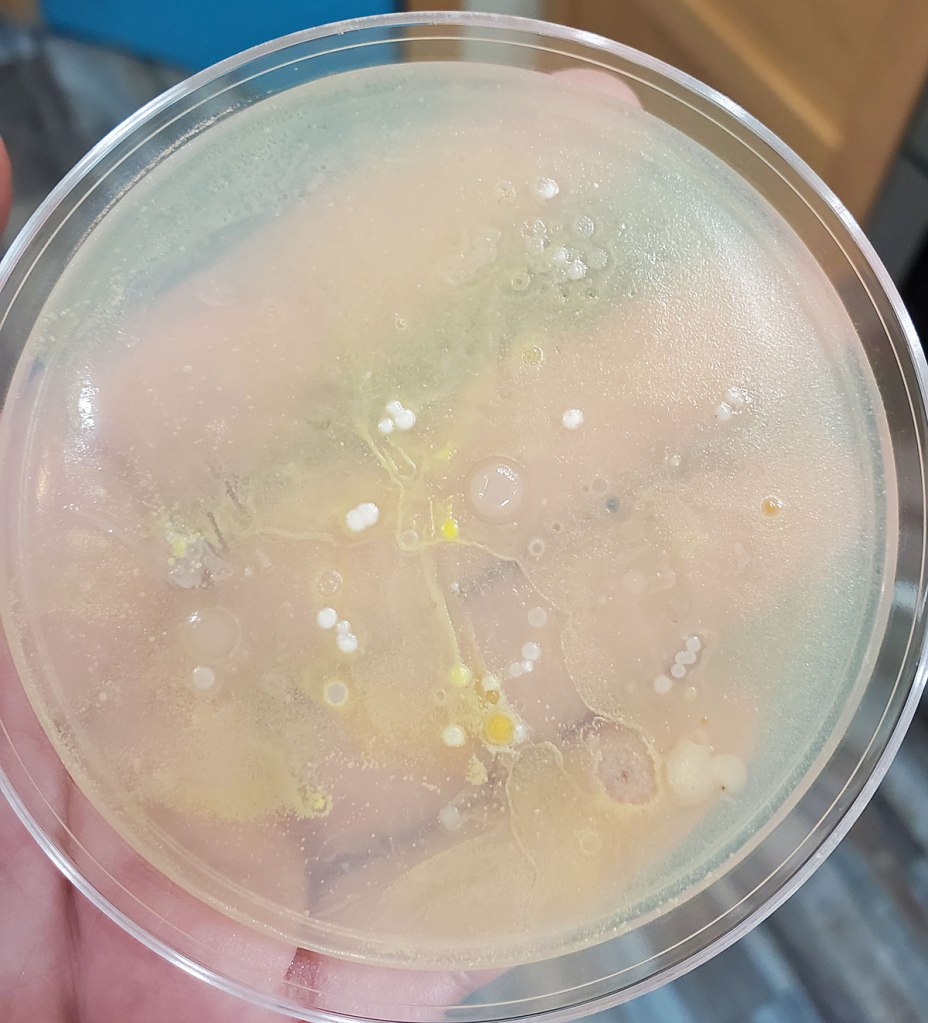
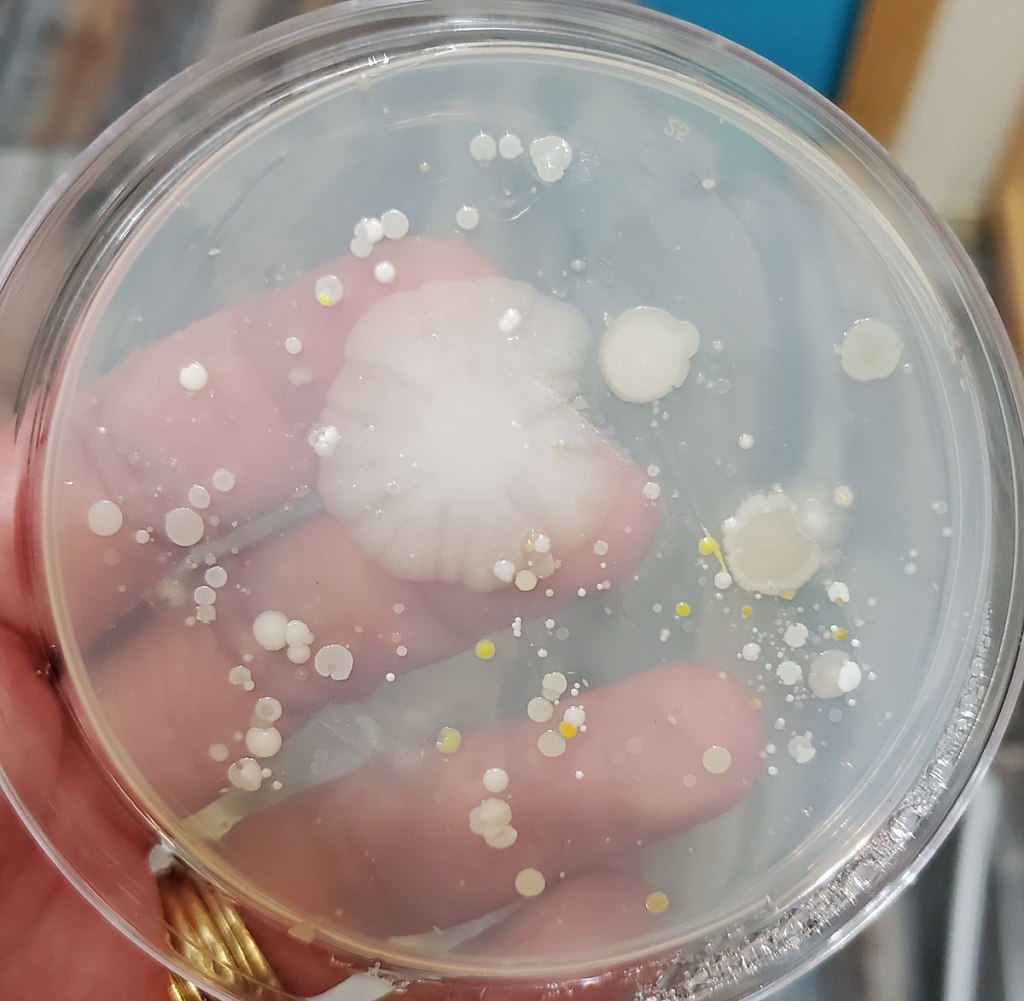
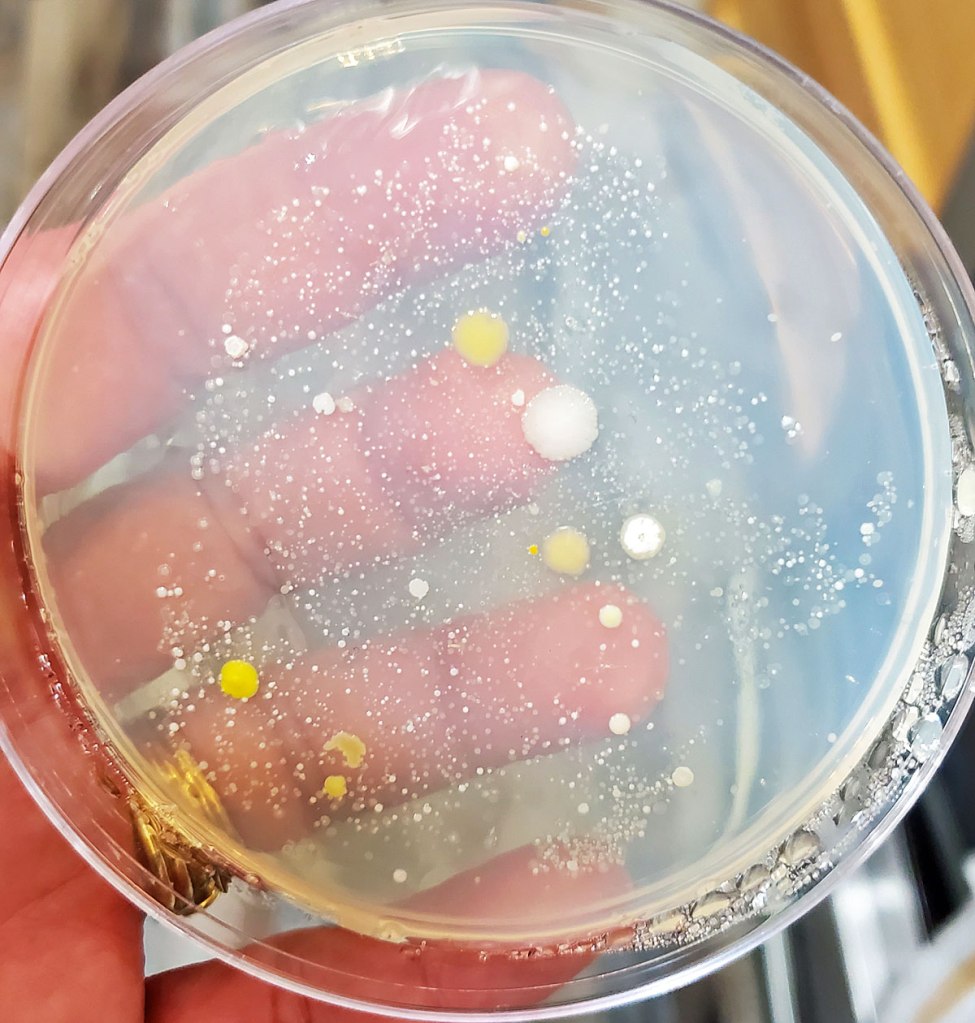
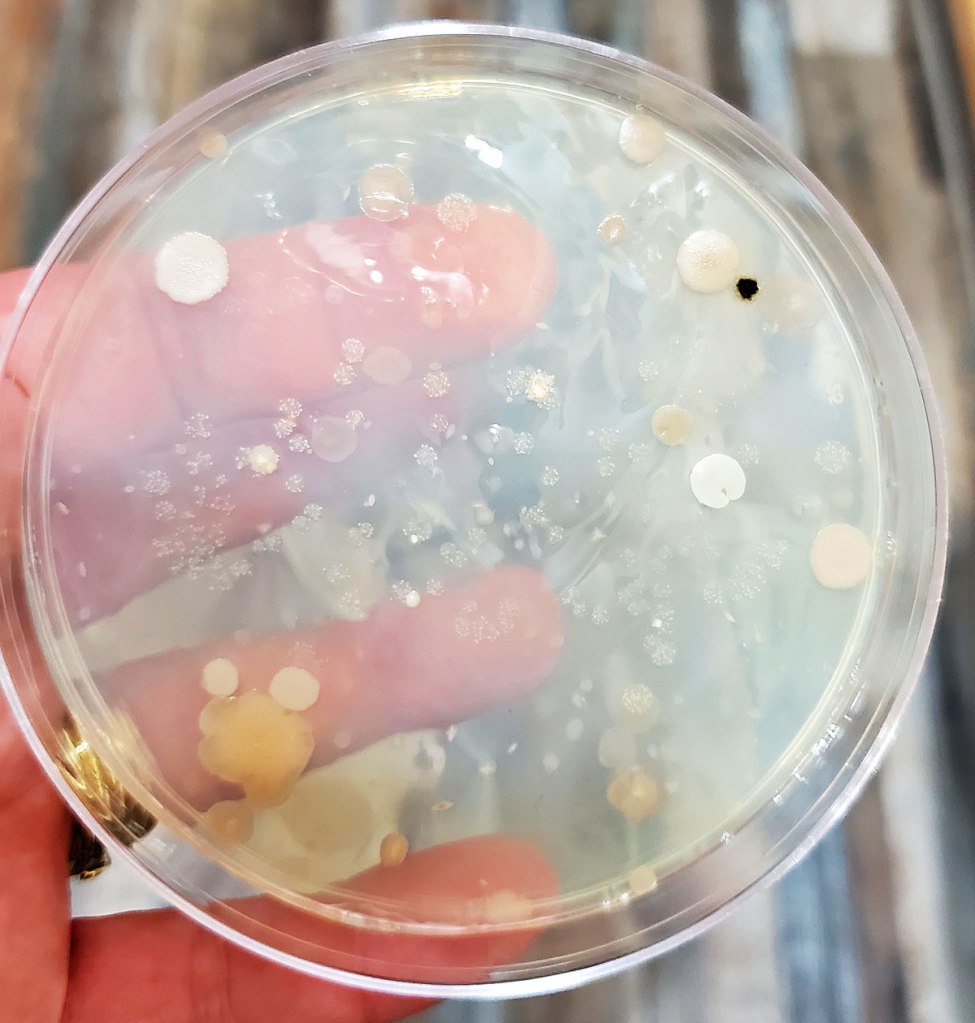

What can I say, I’m inquisitive? Apparently, that’s a fault in this day and age and unfortunately, my quest to alleviate this inquisitiveness, often lands me in places that I don’t usually consider in advance. Especially when I find myself in situations that make me want to toss my cookies.
I admit, that when my kids bring home school assignments that I find interesting, I can’t help but get involved. I know, I’m such a nerd, and after last year’s science fair, I was pumped about this year’s. Sadly, I found myself bummed and deflated when Lola decided not to do one at all and Caelan’s was put on hold…indefinitely.
I think it was ruled out permanently around the end of January or so because the teachers were told to plan on the school being shut down around this time (in April). From this decision, it was decided to get the kids farther ahead in their curriculum for when the lockdowns happen, so science fair got turfed for Caelan’s class. That makes me really sad, I really loved the science fair when I was a kid.
Can you say agar?
Anyway, as I was fully prepared to help Caelan this year, I’d gone ahead and ordered her 20 petri dishes and some agar to fill them with. Talk about exciting! We were going to have some fun and after last year, we were doubly excited because we had real science shit to do it with…like real scientific tools.
Once the supplies arrived, we anxiously awaited to see if the fair was actually going to happen. I’m beginning to think we are too hopeful sometimes 🙂 . Anyway, as you know, it doesn’t always turn out the way we hope and we were left holding the bag…full of petri dishes and agar. Agar is disgusting by the way, blech.
So, we had all the science shit to execute this awesome science fair experiment and no science fair. Bummer. So, what do a couple of gals like Caelan and myself do? That’s right, enjoy a little intellectual playtime.
I’m fascinated…and a little grossed out
I’m including Caelan in this because she was originally the one who was supposed to do all of the work, but when she decided that Fortnite was funner, well I kind of decided to keep playing on my own. Yeah, I know what you’re thinking…Ali is a total weirdo…and yes, I do have a microscope (from when I was a kid), but I never brought it out to play with for this experiment. No, the smell of the agar made me want to vomit and honestly, I didn’t want to have my face that close to whatever the hell was growing in those bloody petri dishes…double yuck.
It’s funny because the shit that was growing in those very petri dishes, was actually stuck to our faces just before I placed it there, and now…well, now, I don’t really wanna leave my house and have that shit stuck to my face when I do. If you haven’t guessed, we decided to see what was growing in the face masks we’ve been wearing for the past how many months now, and let me tell ya, I am grossed the fuck out. Heeebeeejeebbbiiieess….ewww cooties.

Now, please know that we weren’t scientifically controlling shit, we were just merely pissing around, but I must say that what we discovered was pretty nasty. After Caelan used bakery bread to test and see if hand washing was better than using hand sanitizer last year, she decided to take it a step further and see what could possibly be growing in a fabric face mask, after it had been worn. Currently, we use the ones Old Navy sells because we discovered after I’d made a bunch of my own (with the 3 recommended layers and a pocket for a filter), that we were breathing out of the sides of them due to being a little too cootie proof so to speak. Needless to say, I was also tired of wasting my quilting fabric because I needed to make so many (especially if you change them as often as I do) and breathing out the sides completely defeated the purpose of wearing them.
This is how we roll around here
The girls take a clean, unworn mask to school every day (they’re hanging on a hook by the door all ready to go) and when they get home, they are supposed to toss the used masks into the washing machine. I’d like to say that every time we go out we take brand new masks, but I know that Clem will reuse his and keep it in his jacket pocket before throwing it into the wash after a few wears and I’ve had to clean out Caelan’s jacket pockets to retrieve masks when we’ve run out (she uses a new one every day but just stashes them in her pockets after school and then leaves them). I think that’s normal for many, but I prefer to change masks often (especially if they get moist or if I end up touching them because of having to adjust them) and I wash them upon arriving at home (when and or if I ever go anywhere).
The inside of Caelan’s mask after wearing it one time and then stashing in inside her jacket pocket for 2 weeks. 
The outside of the very same mask.
I can speak for myself in saying that when in public without a mask before all of this, I was always cognizant and disciplined about not touching my face and making sure to wash my hands as soon as I got home, consumed anything, or even scratched my face or touched it (I became stringent about this after my kids got stomach bugs for the first time and it has become strictly ritualistic for me since Caelan had cancer). Now, I find that I have no choice some days other than to grab the very least amount of fabric from the very bottom of my mask under my chin to adjust it when it finds its way up and nearly into my eyes (the damned things move) which is especially concerning because I find I have to wear contact lenses when I go out because I can’t stand to wear a mask while wearing my glasses (and now I am wondering what might be finding its way into my eyes after this little experiment).
This is the outside of a mask I wore for maybe 30 minutes…yes, I did touch it and adjust it because of my glasses.
The outside of my mask worn for 2 hours. Something caused some tickling, my nose got runny and voila…yucky.
The inside of my mask worn for 2 hours…boogers and all.
So yeah, this wasn’t done within extremely controlled parameters but it was definitely interesting to say the least. Clem had a beard at the time of our little experiment and instead of using the swabs provided, I just touched or stamped the inside and outside of each mask on to the agar before tossing them in the wash. Not very scientific but we saw some fun things growing to say the least. The outsides of the masks were by far the most disgusting which was no surprise and we let them grow for a few days with a heating pad underneath them…double yum!
I had fun
Let’s just say that after having this experiment growing in my kitchen the last little while, I was happy to dispose of it safely (think bleach) and get it all out of my house. It would’ve been interesting to identify exactly what kind bacteria we had growing but I’m sure that would’ve made my skin crawl a whole lot more than it has. Such an interesting experience and of course, Caelan suggested that I share it with you all because she thought it was absolutely disgusting.
Of course, I had to share a mask from a typical day at school…Caelan’s mask, one school day and this was grown from the INSIDE. 
The same mask but shows what the OUTSIDE was growing…she did say that the mask fell on the floor once and someone stepped on it.
And to think, for a kid who hasn’t changed her handwashing habits from when she had cancer and easily exceeds many of the other protocols at this time, her masks from school were horrid. Honestly, I cannot imagine what the masks look like from the kids that she says come to school wearing the same one for days on end. You know, I feel like buying another set of petri dishes and seeing if we could perhaps borrow one of those masks…you have to admit, you are a little curious…aren’t you?


Dear Hopeful,You should have been a pathologist. If not the new host of Jeopardy.. Sent from Mail for Windows 10 From: The Hopeful PessimistSent: Thursday, April 8, 2021 12:21 AMTo: chuckwords00@gmail.comSubject: [New post] Fun With Mask Cooties thehopefulpessimist posted: " What can I say, Iâm inquisitive? Apparently, thatâs a fault in this day and age and unfortunately, my quest to alleviate this inquisitiveness, often lands me in places that I donât usually consider in advance. Especially when I find myself in situations "
LikeLiked by 1 person
Hi Chuck!
LOL! You know….I have been considering advancing my education in the past few years and that area does intrigue me.
Ooooh Jeopardy! I have to say, that would definitely be fun! 😊 As I’m most certainly not smart enough to answer the questions, asking would definitely suit me LOL!
Ali 😊
LikeLike
Thanks Ali… Now I have to run around the house checking for used snot rags in all of my jacket pockets, purses, and the like!
LikeLiked by 1 person
LOL! Sorry!
I think pockets aren’t too bad because they’re cold and not an incubator like our faces are 😂! It’s still pretty gross though!
Oh and my pockets are always full of used snot rags lol 😝….I won’t lie 😂. Oooh that brings me back to when my mom used to spit on the cleanest one from her pocket and wipe our faces when we were young 😂😂! Kids nowadays have it easy lol! 🤣
LikeLike
I stayed with one of my sister’s for a few months after I graduated. We would watch year jerker movies and share one snot rag because neither of us wanted to get up and miss something. 🤣🤣🤣
LikeLiked by 1 person
LOL! 🤣 That’s hilarious! I’m sure my siblings and I were all born in a barn….Lea would use the inside of her shirt lol! Can’t say that I haven’t done it either 🤣! No pause, rewind or single button record how many years ago…we couldn’t possibly get up and grab snot rags….we’d miss the movie! 🤣 🤣
LikeLike
This is true! Gross.. but true. 🤣🤣🤣
LikeLiked by 1 person
And at the end of the day….what’s a few boogers between sisters 🤣!
LikeLike
Ewww…. 😂
LikeLiked by 1 person
🤣🤣🤣
LikeLike